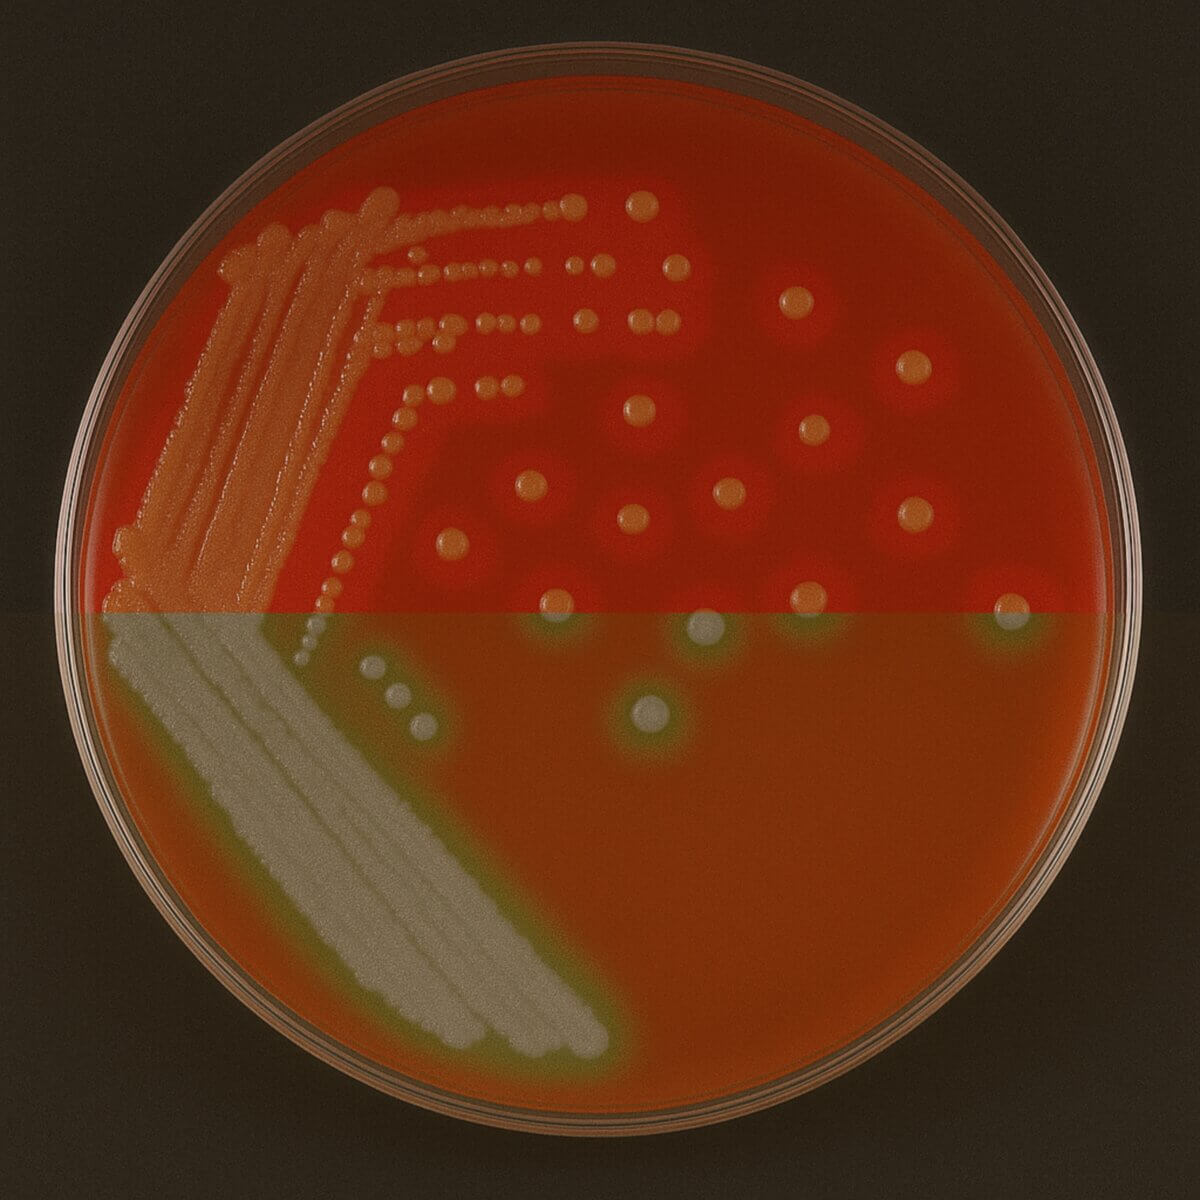
Alpha vs. Beta-Hämolyse

Hämolysierende Streptokokken
Trainier deine Lernmuskeln!
Mit Flash Cards, Quiz und mehr
LoslegenEnglisch: hemolytic streptococci
Definition
Hämolysierende Streptokokken sind Streptokokken, die eine Hämolyse verursachen. Sie werden in α-, β-, und γ-hämolysierend unterteilt.
Klassifizierung nach Brown
In der Lancefield-Klassifikation werden Streptokokken anhand spezifischer Antigen-Antikörper-Reaktionen unterteilt. Darüber hinaus lässt sich nach Brown eine Einteilung nach dem Hämolyseverhalten in einem Nährmedium (z.B. Blutagar) vornehmen.
α-hämolysierende Streptokokken
Es zeigt sich eine grünliche Färbung im Umkreis der Bakterienkulturen. Die Bakterien setzen Wasserstoffperoxid (H2O2) oder Schwefelwasserstoff (H2S) frei. Das Hämoglobin im Agar wird dadurch zu Methämoglobin oxidiert oder zu Sulfhämoglobin umgewandelt, das die grünliche Farbe verursacht.
α-hämolysierende Bakterien besitzen jedoch weder eine Hämoxygenase noch sezernieren sie Hämolysine, können Hämoglobin also nicht vollständig abbauen. Man spricht daher auch von einer inkompletten Hämolyse. α-hämolysierende Streptokokken können u.a. eine infektiöse Endokarditis und Karies hervorrufen.
siehe auch: α-Hämolyse
β-hämolysierende Streptokokken
Hier ist eine helle, gelbliche Färbung des Blutagars zu beobachten. Anders als α-hämolysierende Bakterien besitzen diese Bakterien eine Hämoxygenase und Hämolysine. Die Sekretion dieser Exotoxine verursacht die Hämolyse. Das dadurch freiwerdende Hämoglobin wird aufgenommen und enzymatisch erst zum Biliverdin und danach zum gelblichen Bilirubin abgebaut. Für diese Bakterien ist Eisen überlebensnotwendig, weshalb sie das Hämoglobin ihres Wirtes als Eisenquelle nutzen. Eine Infektion mit β-hämolysierenden Streptokokken kann zu Scharlach und Angina tonsillaris führen.
siehe auch: β-Hämolyse
γ-hämolysierend
Diese Bakterien wirken nicht zytotoxisch und verursachen auch keine Hämolyse.
siehe auch: γ-Hämolyse
Beispiele
| α-Hämolyse | β-Hämolyse | γ-Hämolyse |
|---|---|---|
| Streptococcus pneumoniae | Streptococcus pyogenes | Enterococcus faecalis |